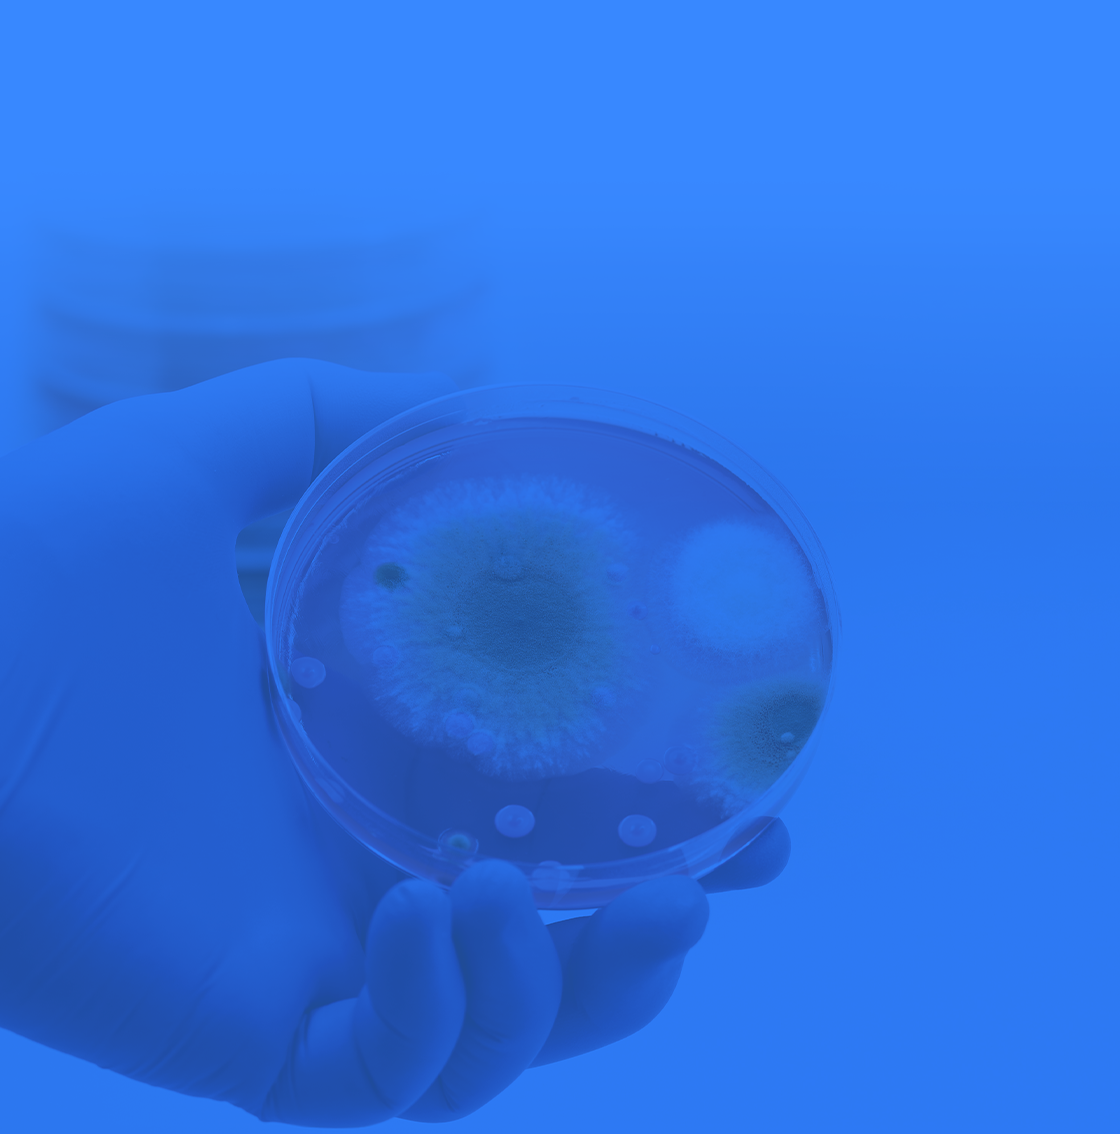

매거진
세스코에서 제공하는 다양한 정보를 확인해 보세요.
세스코 라이프케어 매거진 vol 10
2025.12.10VOLUME 10 CESCO lifecare Magazine by CESCO SCIENCE

CESCO Lifecare Magazine
방치하면 호흡기 질환의원인이 될 수 있는 실내 곰팡이,
겨울철 곰팡이 확산을 막는 관리 방법
![[라이프케어] 창문에 결로가 생겨 창문과 창틀에 맺혀 있는 사진입니다.](https://www.cescomall.co.kr/upload/editor/20251209/1d149b61-195a-4dc5-a408-fac1617f4a212/editor.png)
01
Q&A
All about
곰팡이,
세스코에게 묻고 답하다
곰팡이,
세스코에게 묻고 답하다
Q.
곰팡이, 습한 여름에만 발생하는 것 아닌가요?
곰팡이는 온도가 높고 습한 환경을 좋아
하여 주로 여름 장마철에 많이 발생합니다. 그러나
실내에 물방울이 맺히는 현상으로, 날씨가 추운 겨울
난방기기를 가동하면서 바깥과 내부의 온도차가
커져 발생합니다. 특히 외부와 가까운 천장, 벽, 창문
주변 등은 결로 현상으로 인해 곰팡이가 더 자주
발생할 수 있는 공간입니다. 곰팡이는 높은 습도,
수분 등 곰팡이가 필요로 하는 약간의 영양분만
있다면 실내 식물, 벽, 바닥 등 어디에나 자랄 수 있어
실내를 항상 청결하게 관리하는 것이 중요합니다.
하여 주로 여름 장마철에 많이 발생합니다. 그러나
겨울에도 결로 현상으로 인해
실내에 곰팡이가
발생할 수 있습니다.
결로 현상이란 실내와 실외의 온도차가 커지면서실내에 곰팡이가
발생할 수 있습니다.
실내에 물방울이 맺히는 현상으로, 날씨가 추운 겨울
난방기기를 가동하면서 바깥과 내부의 온도차가
커져 발생합니다. 특히 외부와 가까운 천장, 벽, 창문
주변 등은 결로 현상으로 인해 곰팡이가 더 자주
발생할 수 있는 공간입니다. 곰팡이는 높은 습도,
수분 등 곰팡이가 필요로 하는 약간의 영양분만
있다면 실내 식물, 벽, 바닥 등 어디에나 자랄 수 있어
실내를 항상 청결하게 관리하는 것이 중요합니다.
Q.
곰팡이, 무엇이 문제인가요?
실내에 곰팡이가 발생하면 곰팡이 포자가 부유하면서
문제가 발생합니다. 곰팡이는 부유곰팡이 포자로
공간에 번식하는데, 이 포자가 호흡기를 통해 인체로
들어올 경우 문제가 발생합니다.
환경부에서 2018년부터 사람들이 많이 모이는 다중
이용시설 실내 공기질 권고기준 항목에 부유곰팡이
항목을 추가하여 실내 공기 오염을 파악하고 있을
정도로 실내 공기질 오염을 파악하는 데에 곰팡이
유무가 중요한 기준으로 작용하고 있습니다. 환경부는
세계보건기구(WHO) 권고기준에 따라 총 부유
곰팡이 500 CFU/m3를 권고기준 농도로 설정하고
실내 공기질 관리법을 개정하여 시행 중입니다.
또, 국립환경과학원은 부유곰팡이는 계절적으로
차이가 있지만 벽지나 먼지에 섞인 곰팡이는 계절에
상관없이 상존하고, 장기간 노출될 경우 영향을 받을
수 있다고 밝혔습니다.
문제가 발생합니다. 곰팡이는 부유곰팡이 포자로
공간에 번식하는데, 이 포자가 호흡기를 통해 인체로
들어올 경우 문제가 발생합니다.
환경부에서 2018년부터 사람들이 많이 모이는 다중
이용시설 실내 공기질 권고기준 항목에 부유곰팡이
항목을 추가하여 실내 공기 오염을 파악하고 있을
정도로 실내 공기질 오염을 파악하는 데에 곰팡이
유무가 중요한 기준으로 작용하고 있습니다. 환경부는
세계보건기구(WHO) 권고기준에 따라 총 부유
곰팡이 500 CFU/m3를 권고기준 농도로 설정하고
실내 공기질 관리법을 개정하여 시행 중입니다.
또, 국립환경과학원은 부유곰팡이는 계절적으로
차이가 있지만 벽지나 먼지에 섞인 곰팡이는 계절에
상관없이 상존하고, 장기간 노출될 경우 영향을 받을
수 있다고 밝혔습니다.
Q.
실내 곰팡이로 인해 호흡기 질환에
걸릴 수도 있다고요
세계보건기구(WHO)와 미국 의학연구원에
곰팡이는 천식, 아토피 피부염, 만성 호흡기 질환 등
알레르기 질환을 일으키는 물질로 규정되어 있습니다.
곰팡이는 건강에 해가 될 수 있는 화학물질과 포자를
방출해 호흡기 증상을 유발하는데, 곰팡이에 민감한
사람이라면 노출될 경우 일시적으로 코막힘이나
눈 가려움, 호흡곤란, 숨막힘, 피부의 자극 등의
증상이 나타날 수 있습니다.
면역력이 약한 사람들은 곰팡이로 인해
아스페르길루스 감염증에 감염될 수도 있습니다.
아스페르길루스 감염증은 아스페르길루스라는
곰팡이의 포자가 공기 중을 떠다니다가 호흡기를 통해
인체로 들어와 호흡기가 감염되는 질병입니다.
아스페르길루스에 의한 감염은 곰팡이 감염 중
가장 흔한 질병이며 흡입이 주된 경로이므로 폐렴
형태로 발병해 혈관을 통해 간, 비장, 신장, 근골격계
등 모든 장기까지 퍼져 나갈 수 있습니다.
건강한 사람들은 이 곰팡이 포자에 노출되어도
문제가 발생하지 않지만 면역 기능에 문제가 있는
사람들은 감염될 수 있고, 면역저하 환자들은 곰팡이
감염으로 인한 사망률이 매우 높게 나타나므로
더욱 주의가 필요합니다.
더불어 2020년 고려대학교 안암병원 천식환경
보건센터 연구팀이 천식 환자 20명을 대상으로
연구한 결과 가정 내 곰팡이에 노출될 경우 기도가
과민하게 반응하는 현상을 높여 천식 발생의 위험과
증상을 키울 수 있는 것으로 나타나 호흡기 질환
환자들에게는 실내 곰팡이 관리가 더욱 중요할
것으로 보입니다.
곰팡이는 천식, 아토피 피부염, 만성 호흡기 질환 등
알레르기 질환을 일으키는 물질로 규정되어 있습니다.
곰팡이는 건강에 해가 될 수 있는 화학물질과 포자를
방출해 호흡기 증상을 유발하는데, 곰팡이에 민감한
사람이라면 노출될 경우 일시적으로 코막힘이나
눈 가려움, 호흡곤란, 숨막힘, 피부의 자극 등의
증상이 나타날 수 있습니다.
면역력이 약한 사람들은 곰팡이로 인해
아스페르길루스 감염증에 감염될 수도 있습니다.
아스페르길루스 감염증은 아스페르길루스라는
곰팡이의 포자가 공기 중을 떠다니다가 호흡기를 통해
인체로 들어와 호흡기가 감염되는 질병입니다.
아스페르길루스에 의한 감염은 곰팡이 감염 중
가장 흔한 질병이며 흡입이 주된 경로이므로 폐렴
형태로 발병해 혈관을 통해 간, 비장, 신장, 근골격계
등 모든 장기까지 퍼져 나갈 수 있습니다.
건강한 사람들은 이 곰팡이 포자에 노출되어도
문제가 발생하지 않지만 면역 기능에 문제가 있는
사람들은 감염될 수 있고, 면역저하 환자들은 곰팡이
감염으로 인한 사망률이 매우 높게 나타나므로
더욱 주의가 필요합니다.
더불어 2020년 고려대학교 안암병원 천식환경
보건센터 연구팀이 천식 환자 20명을 대상으로
연구한 결과 가정 내 곰팡이에 노출될 경우 기도가
과민하게 반응하는 현상을 높여 천식 발생의 위험과
증상을 키울 수 있는 것으로 나타나 호흡기 질환
환자들에게는 실내 곰팡이 관리가 더욱 중요할
것으로 보입니다.
우리집 벽지, 창 틈, 천장 등의 곰팡이가 걱정이신가요?
세스코가 고객님 공간에 딱 맞춘
곰팡이 관리 방법을 안내해 드립니다.
환경위생진단 신청하기
세스코가 고객님 공간에 딱 맞춘
곰팡이 관리 방법을 안내해 드립니다.

![[라이프케어] 연구원의 뒷모습의 어깨 너머로 연구원들이 연구하고 있는 모습이 멀리에 보이고 흐림 처리 되어있습니다.](https://www.cescomall.co.kr/upload/editor/20250304/726ffe45-71df-4f06-a9c2-787ca56750f721/editor.png)
02
Self
Solution
세스코가 알려드리는
실내 곰팡이 예방법
실내 곰팡이 예방법
추운 겨울,
쾌적한 실내 생활을 위한
곰팡이 셀프 관리 가이드
쾌적한 실내 생활을 위한
곰팡이 셀프 관리 가이드
![[라이프케어] 환기를 위해 창문을 열고 있습니다.](https://www.cescomall.co.kr/upload/editor/20251209/1d149b61-195a-4dc5-a408-fac1617f4a214/editor.png)
TIP. 1
주기적으로 창문을 열어
실내 공기 환기하기
겨울철 결로 현상으로 인한 곰팡이 번식을 막기
위해서는 실내 온도와 습도를 적절하게 조절하는
것이 가장 중요합니다.
온도는 20~22℃, 습도는 40~60%로 유지해 주는
것이 좋고, 춥더라도 적절한 실내 습도 유지를 위해
최소 10분 이상 주기적으로 창문을 열어 환기해 주세요.
겨울철에는 실내가 건조할 때 빨래를 널어 두거나
가습기를 틀어 습도를 높이기도 하는데
습도가 지나치게 높아질 경우 곰팡이가 발생하기
쉬우니 주의해야 합니다.
위해서는 실내 온도와 습도를 적절하게 조절하는
것이 가장 중요합니다.
온도는 20~22℃, 습도는 40~60%로 유지해 주는
것이 좋고, 춥더라도 적절한 실내 습도 유지를 위해
최소 10분 이상 주기적으로 창문을 열어 환기해 주세요.
겨울철에는 실내가 건조할 때 빨래를 널어 두거나
가습기를 틀어 습도를 높이기도 하는데
습도가 지나치게 높아질 경우 곰팡이가 발생하기
쉬우니 주의해야 합니다.
![[라이프케어] 창문에 생긴 결로를 확대하여 찍은 사진입니다.](https://www.cescomall.co.kr/upload/editor/20251209/1d149b61-195a-4dc5-a408-fac1617f4a215/editor.png)
TIP. 2
창문이나 문 틈에
결로 방지 테이프 붙여주기
실외와 맞닿아 있는 창문이나 문 틈은 다른 공간에
비해 결로 현상이 발생하기 더욱 쉽습니다.
따라서 그때그때 맺힌 물방울을 처리해 주는 것이
중요한데요. 이때 틈에 결로 방지 테이프를 붙여주면
창문에 맺힌 물방울을 테이프가 흡수하고 자연 건조를
통해 처리해 주어 창문에 곰팡이가 생기는 것을
방지해 줄 수 있습니다.
비해 결로 현상이 발생하기 더욱 쉽습니다.
따라서 그때그때 맺힌 물방울을 처리해 주는 것이
중요한데요. 이때 틈에 결로 방지 테이프를 붙여주면
창문에 맺힌 물방울을 테이프가 흡수하고 자연 건조를
통해 처리해 주어 창문에 곰팡이가 생기는 것을
방지해 줄 수 있습니다.
![[라이프케어] 행거에 세스코 마이랩 습기제거제 스탠드형을 걸고 있습니다.](https://www.cescomall.co.kr/upload/editor/20251209/1d149b61-195a-4dc5-a408-fac1617f4a216/editor.png)
TIP. 3
옷장, 주방 등 습한 공간에는
제습제 등 습기 제거 물품 비치하기
환기가 잘되지 않는 옷장 속이나 물기가 항상
남아있어 습한 주방은 곰팡이가 번식하기 쉬운
장소입니다.
두꺼운 겨울옷들은 습기를 머금고, 공기가 제대로
순환되지 않아 곰팡이가 번식하기 쉬워 습기 제거가
반드시 필요합니다. 옷장에는 걸어 둘 수 있는
제습제를 비치하여 습기를 제거해 주거나 신문지, 숯
등을 이용하는 것도 겨울철 습기로 인한 곰팡이를
방지하는 데에 도움이 될 수 있습니다.
남아있어 습한 주방은 곰팡이가 번식하기 쉬운
장소입니다.
두꺼운 겨울옷들은 습기를 머금고, 공기가 제대로
순환되지 않아 곰팡이가 번식하기 쉬워 습기 제거가
반드시 필요합니다. 옷장에는 걸어 둘 수 있는
제습제를 비치하여 습기를 제거해 주거나 신문지, 숯
등을 이용하는 것도 겨울철 습기로 인한 곰팡이를
방지하는 데에 도움이 될 수 있습니다.
![[라이프케어] 창문에 생긴 결로를 닦아 내고 있습니다.](https://www.cescomall.co.kr/upload/editor/20251209/1d149b61-195a-4dc5-a408-fac1617f4a217/editor.png)
TIP. 4
천장, 벽 등에 맺힌 물방울은
곧바로 닦아내기
천장, 벽 등에 맺힌 물방울은 방치할 경우 곰팡이의
원인이 될 수 있기 때문에 곧바로 닦아주어야 합니다.
벽지가 물기를 머금었다면 선풍기나 드라이기를
이용해 말려주는 것도 곰팡이를 방지할 수 있는
좋은 방법입니다.
특히 결로가 자주 발생하는 공간은 물방울이
그대로 방치되지 않도록 신경 써서 관리해 주세요
원인이 될 수 있기 때문에 곧바로 닦아주어야 합니다.
벽지가 물기를 머금었다면 선풍기나 드라이기를
이용해 말려주는 것도 곰팡이를 방지할 수 있는
좋은 방법입니다.
특히 결로가 자주 발생하는 공간은 물방울이
그대로 방치되지 않도록 신경 써서 관리해 주세요
![[라이프케어] 곰팡이가 생긴 곳에 세스코 마이랩 곰팡이 제거제를 사용하고 있습니다.](https://www.cescomall.co.kr/upload/editor/20251209/1d149b61-195a-4dc5-a408-fac1617f4a216/editor.png)
TIP. 5
곰팡이가 생겼다면, 더 퍼지지
않도록 즉시 제거해 주며 관리하기
창문 틈, 벽지 등에 생긴 곰팡이는 방치했다간
더 넓은 영역에까지 퍼져나갈 수 있습니다.
따라서 곰팡이를 발견했다면 그 즉시 퍼지지 않도록
곰팡이 제거제를 이용해 제거해 주세요.
벽지 곰팡이는 알코올과 물을 1:4 비율로 섞어 뿌리고,
10분 뒤 마른 걸레로 닦아내 주는 것도 도움이 됩니다.
젖은 걸레로 곰팡이를 닦을 경우 포자가 주변으로
번질 수도 있으니 주의해 주세요.
더 넓은 영역에까지 퍼져나갈 수 있습니다.
따라서 곰팡이를 발견했다면 그 즉시 퍼지지 않도록
곰팡이 제거제를 이용해 제거해 주세요.
벽지 곰팡이는 알코올과 물을 1:4 비율로 섞어 뿌리고,
10분 뒤 마른 걸레로 닦아내 주는 것도 도움이 됩니다.
젖은 걸레로 곰팡이를 닦을 경우 포자가 주변으로
번질 수도 있으니 주의해 주세요.

실내 곰팡이 없는 따뜻한 겨울을 보내기 위해
Self Solution은 가장 기본적인 위생 수칙입니다.
그러나, 단순한 오염처럼 보이지만 한 번 발생하면
빠르게 번식해 공기 중 부유하는 포자로
호흡기 질환을 유발하는 곰팡이.
Self Solution은 가장 기본적인 위생 수칙입니다.
그러나, 단순한 오염처럼 보이지만 한 번 발생하면
빠르게 번식해 공기 중 부유하는 포자로
호흡기 질환을 유발하는 곰팡이.
그래서 세스코는,
눈에 보이는 곰팡이 얼룩에만
집중하는 것이 아니라
곰팡이가 서식하는 공간의
오염원인을 분석하고
유해세균과 곰팡이균까지
99.9% 제거하는 살균과학을
연구합니다.
집중하는 것이 아니라
곰팡이가 서식하는 공간의
오염원인을 분석하고
유해세균과 곰팡이균까지
99.9% 제거하는 살균과학을
연구합니다.

03
CESCO
Professional
Solution
곰팡이균의 서식환경까지 연구하여 개발한
세스코 생활과학 연구소의 솔루션으로
세스코 생활과학 연구소의 솔루션으로
실내 곰팡이에서 벗어나 위생적이고
따뜻하게 월동준비 완료
따뜻하게 월동준비 완료
STEP. 1
지우기 힘든 묵은 곰팡이도
바르고 닦으면 쉽게 해결
바르고 닦으면 쉽게 해결
세스코 마이랩
곰팡이제거제

흑곰팡이, 푸른곰팡이, 흑효모 등
실리콘 깊이 박혀
지우기 힘든 곰팡이도
쉽게 제거1)
지우기 힘든 곰팡이도
쉽게 제거1)
곰팡이균은 기본,
눈에 보이지 않는
유해세균2) 까지
99.9% 살균
유해세균2) 까지
99.9% 살균

CHECK POINT.
-

가습기 살균제 이슈 성분 4종
(CMIT, MIT, BKC, DDAC) 불검출3) -

꿉꿉한 냄새는 물론 악취의 원인까지 제거
-

흘러내리지 않는 겔 타입으로 수직 · 경사
벽면에도 편리하게 사용 가능 -

뾰족한 토출구 설계로 틈새, 모서리, 굴곡진 곳 등
꼼꼼하고 쉽게 도포 가능
-
1) 흑곰팡이(Aspergillus brasiliensis ATCC 16404)
흑곰팡이(Aspergillus niger ATCC 6275),
푸른곰팡이(Talaromyces pinophilus ATCC 11797),
흑효모(Aureobasidium pullulans ATCC 15233) -
2) 대장균(Escherichia Coli ATCC 25922),
황색포도상구균(Staphylococcus aureus) 99.9% 살균 -
3) 가습기 살균제 이슈 성분 4종(CMIT 클로로메틸이소티아졸리논,
MIT 메틸이소치아졸리논, BKC 염화벤잘코늄, DDAC 암모늄클로라이드) /
시험기관 : KCL
STEP. 2
공기 중 부유하는 곰팡이균을 비롯해
각종 세균·바이러스 선제
각종 세균·바이러스 선제
세스코 UV파워
공기살균기 Sense me

공기 중 떠다니는 곰팡이균을 비롯해
환절기 독감을 유발하는
환절기 독감을 유발하는
인플루엔자 바이러스
99.99% 살균1)
99.99% 살균1)
호흡기 질환을 유발하는
폐렴균
99.99% 살균2)
99.99% 살균2)
사람을 공격하기 전,
세스코 공기살균기가
세균 · 바이러스를 선제 살균!
세스코 공기살균기가
세균 · 바이러스를 선제 살균!
공기 중 곰팡이 분사 시험*

* 공기 중 곰팡이 분사 시험
1. 본 실험 결과는 제한된 조건에서 진행된 실험으로 다른 환경에서의
살균 성능은 사용 환경에 따라 다를 수 있습니다.
2. 실험 조건 : 실험군(공기살균기를 켜둔 환경)은 0.12m3 챔버에
약 5 x 103 CFU/m3 농도로 곰팡이(A. niger) 분사 후,
센스미 1시간 가동 후 토마토 거치. 이후, 센스미를 지속적으로 켜 둔 환경에서
온도 약 25도, 습도 50~55% 조건에서 6일동안 토마토 관찰
: 대조군(일반 환경)은 실험군과 세부 조건은 동일하며,
센스미 작동 없이 바로 토마토 거치 후 6일동안 관찰
1. 본 실험 결과는 제한된 조건에서 진행된 실험으로 다른 환경에서의
살균 성능은 사용 환경에 따라 다를 수 있습니다.
2. 실험 조건 : 실험군(공기살균기를 켜둔 환경)은 0.12m3 챔버에
약 5 x 103 CFU/m3 농도로 곰팡이(A. niger) 분사 후,
센스미 1시간 가동 후 토마토 거치. 이후, 센스미를 지속적으로 켜 둔 환경에서
온도 약 25도, 습도 50~55% 조건에서 6일동안 토마토 관찰
: 대조군(일반 환경)은 실험군과 세부 조건은 동일하며,
센스미 작동 없이 바로 토마토 거치 후 6일동안 관찰
CHECK POINT.
-

세스코 첨단 과학으로 개발한 UV살균터널™
-

환절기 독감 유발 인플루엔자(H1N1) 바이러스,
코로나 바이러스 99.99%1) 살균 -

호흡기 질환 유발 폐렴균 99.9%2) 살균
-

사람의 움직임을 감지하고 살균하는
스마트케어 기술
-
1) 세스코 과학연구소와 고려대 의대 바이러스병 연구소의 공동연구. 살아있는
고위험 바이러스를 실제로 다룰 수 있는 BSL-3 시설을 갖춘 고려대 바이러스병
연구소에서 880L 특수 챔버에 코로나19 바이러스, 신종 인플루엔자 바이러스를
공기 중 부유시킨 뒤, 공기살균기를 30분간 가동한 전·후의 바이러스 제거 효능을
3회 비교 평가. 공기 중 코로나19 바이러스, 인플루엔자(H1N1) 바이러스
99.99% 살균(UV파워 공기살균기 Sense me, UV파워 공기살균기 시험 완료) -
2) 한국건설생활환경시험연구원에서 폐렴균
(klebsiella pneumoniae ATCC 4352)에 대해 시험분석. 8m3 챔버 내부 중앙에
공기살균기 Sense me를 위치 시킨 후 폐렴균을 공기 중 부유시켜 초기 부유
세균 농도와 공기살균기 2시간 동안 가동 후 농도를 비교. 부유 세균 저감 시험
결과 99.9% 감소 -
※ 상기 살균율은 제한된 실험 조건에서 측정한 결과이며, 실제 사용 환경
(공간 크기, 공기 유입량, 설치 위치 등)에 따라 성능이나 효과가 달라질 수 있습니다.
STEP. 3
바이러스, 세균, 곰팡이 증식 억제 기능까지
3 UP 필터 시스템
3 UP 필터 시스템
세스코 공기청정기

(IoT/라돈플러스)

환기가 어려운 추운 겨울,
알러지가 걱정되는
우리집 공간에는?
알러지가 걱정되는
우리집 공간에는?
곰팡이부터 동물성, 식물, 꽃가루,
집먼지 진드기까지
집먼지 진드기까지
알러지원을 흡착하는
알레르겐 필터로
맞춤 청정케어
알레르겐 필터로
맞춤 청정케어
고성능 H13 구리헤파 필터로
바이러스, 세균, 곰팡이
바이러스, 세균, 곰팡이
증식 억제 기능까지 더한
강력한 필터 시스템
강력한 필터 시스템

CHECK POINT.
-

라돈, CO2, VOCs 등 공기중 유해물질 감지
초정밀 센서 탑재 -

구리헤파 필터의 강력한 청정! 극초미세먼지
99.98% 제거와 바이러스1), 세균2), 곰팡이3)
증식 억제까지 -

모바일 IoT로 편리한 원격 제어,
우리집 공기질 리포트 제공 -

4가지 기능성 필터 중 우리집에 딱 맞는
맞춤형 필터로 공기질 케어
-
1) 바이러스 불활성화 시험 조건
1. 시험대상 : 구리헤파 필터 | 2. 시험내용 : 구리 항균 섬유로 제작된 필터 내
바이러스 불활성화 | 3. 시험결과 : 99.99% | 4. 시험균주 : Influenza A virus
(H3N2) | 5. 시험방법 : ASTM E1052-20 | 6. 시험조건 : 시료명
Q+(나일론99%+CuS1%) 1g과 멸균증류수 20mL 혼합하고 상온에서
24시간 방치 후, 이를 시험용액으로 사용 | 7. 숙주세포 : MDCK(NBL-2),
ATCC CCL-34 | 8. 시험기관 : 한국화학융합시험연구원 -
2) 항균 증식 억제 시험 조건
1. 시험대상 : 구리헤파 필터 | 2. 시험내용 : 구리 항균 섬유로 제작된 필터의
시편을 이용한 필터 내 세균 증식 억제 | 3. 시험결과 : 99.9% | 4. 시험균주 :
Staphylococcus aureus ATCC 6538(황색포도상구균), Klebsiella
pneumonia ATCC 4352(폐렴간균) | 5. 시험방법 : KS K 0693:2016 | 6.
시험조건 : 시험 대상 필터 시편에 시험균을 주입 후 18시간 동안 접촉한 뒤
항균력이 없는 표준 면포와 비교해 억제 정도를 계산 | 7. 시험기관 : FITI
시험연구원 -
3) 항곰팡이 증식 억제 시험 조건
1. 시험대상 : 구리헤파 필터 | 2. 시험내용 : 구리 항균 섬유로 제작된 필터 내
곰팡이 저항성 | 3. 시험결과 : 0등급 | 4. 시험균주 : 혼합균주 Aspergillus
niger ATCC 6275, Penicillium funiculosum CMI 114933,
Paecilomyces variotii ATCC 18502, Gliocladium virens ATCC 9645,
Chaetomium globosum ATCC 6205 | 5. 시험방법 : ISO 846:1997
(Method A) | 6. 시험조건 : ISO 846:1997(Method A) |
7. 시험기관 : 한국화학융합시험연구원
※ 실험실 측정 기준으로 실사용 환경에서는 달라질 수 있습니다.















































